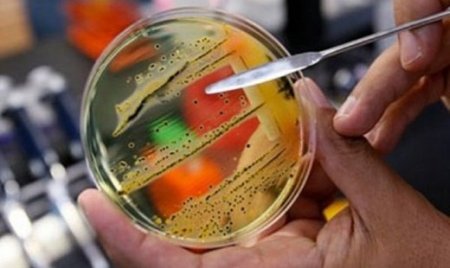
В Первоуральске нарушения санитарных требований в школах носят массовый характер

В Первоуральске нарушения санитарных требований в школах носят массовый характер
8-10-2013, 22:50
фото:
|
Что есть и что пить?!
Нарушения санитарных требований носят массовый характер! Такой вывод сделали специалисты Роспотребнадзора после проверки пищеблоков городских школ Первоуральска. Озвучили санврачи и новые факты массового заболевания детей и взрослых из поселка Прогресс. Пострадавших от опасной инфекции насчитывается 46 человек.
Эпидемиологи поставили диагноз, что это все-таки была вспышка пищевым путем передачи связана с продукцией пищеблока. Подтверждением тому стало и то, что двое носителей инфекции были сотрудники пищеблока.
Кишечные палочки обнаружены были даже в компоте. По информации специалистов Роспотребнадзора, оборудование пищеблока школьной столовой позволяет готовить пищу лишь из полуфабрикатов. Это условие не соблюдалось.
В результате многочисленных нарушений возбужден ряд административных дел. В том числе и в отношении городской больницы №2, где должны были прививаться работники столовой. Только пострадавшим школьникам и родителям, которые заразились уже от своих детей, от этого не легче. Осложнения от полученной инфекции могут быть самыми разными, в том числе и переход в хроническую форму.
При этом, специалисты Роспотребнадзора говорят, что подобное могло случиться и в других общеобразовательных учреждениях.
В каждой второй школе при организации питания выявлены серьезные нарушения.
Но ни чиновники администрации Первоуральска, ни представители управления образования не торопятся их устранять.
На замечания Роспотребнадзора реакции нет.
@ www.pervo.ru
Лента новостей
fdgdfgdfgdfgdfgdfgdfgdfgdfgfdgПосетители, находящиеся в группе Гости, не могут оставлять комментарии к данной публикации.
